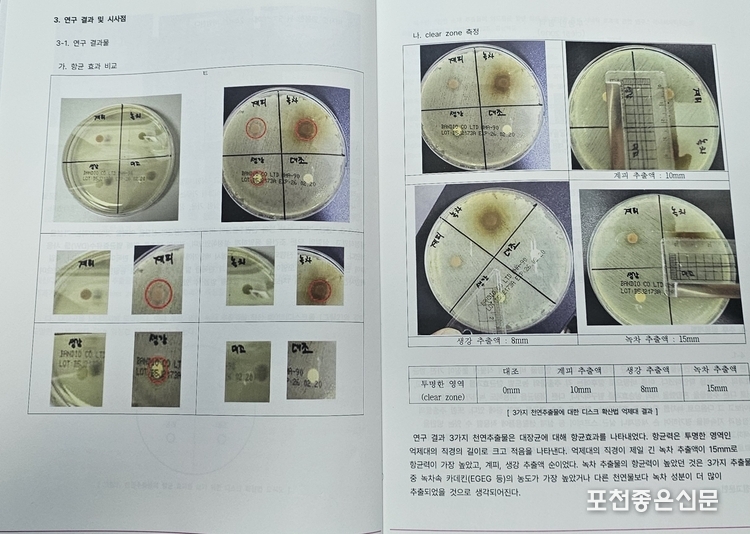

경기도포천교육지원청(교육장 소성숙)은 지난 11월 21~22일, 이틀에 걸쳐 포천교육지원청 및 포천종합체육관 등에서 ‘2025 포천 미래 ON 에듀페어’를 개최했다.



작년까지는 ‘수·정·과(수학·정보·과학) 체험전’이라고 이름 지어진 행사를 제5회차까지 진행했었는데, 학생들이 스스로 체험전을 준비하여 다른 학생들이 체험을 하는 방향의 행사였다. 이를 통해 준비하는 학생들은 자신이 준비한 체험을 원활히 진행하기 위해 한 분야에 깊이 들어가서 공부를 하는 계기가 되었고, 체험을 하는 학생들은 평소 어렵게 여기던 학습적 부분에 대해 쉽고 재미있게 체험을 하는 행사였다.
이 행사를 3~4년 동안 준비한 학생들이 이를 통해 입시에서 도움을 받았다는 사례도 많이 볼 수 있었다. 다만, 아쉬운 점은 학생이 준비하고, 학생이 체험하는 행사라는 취지 때문에 또다른 교육 공동체인 교사들과 학부모 등이 소속된 지역 공동체는 조언자와 후원자의 역할로 약간 뒤에 물러나 있는 듯 한 모양새가 있었다.
하지만, 신임 소성숙 교육장은 과감하게 예산과 행정력을 투입해 ‘2025 포천 미래 ON 에듀페어’로 개편해서 이틀 간의 행사로 확대하였다.
첫날인 21일에는 ‘지역 ON’이라는 이름으로 교사들이 공부하고 연구하는 행사로 만들어냈다.
그리하여 학교·지역·교육공동체가 함께 만들어 온 포천 지역교육협력의 성과를 나누기 위한 교육공동체 좌담회를 개최하였다. 이후 연세대학교 국제학대학원 모종린 교수의 초청 강연을 통해 지속 가능한 교육 발전 방향을 모색하는 시간이 되었다. 이후 저녁 시간에는 포천종합운동장에서 가족과 함께 하는 천문 관측 캠프가 이어졌다.






둘째날인 22일에는 포천종합체육관 및 주차장 공간을 활용하여 관내 중․고등학교 학생들이 직접 운영하는 수학·정보·과학·디지털 체험전‘을 ’미래 ON’이라는 이름으로 바꾸고 학생들이 준비한 한 AI․디지털 기반 체험 부스 위주의 행사가 진행되었다.

행사는 개회식, 소논문 발표회, 부스 체험 등의 순으로 진행되었다. 개회식에는 백영현 시장, 임종훈 의장, 소성숙 교육장, 김용태 국회의원과 시의원 및 도의원, 경기도 교육청 관계자등이 함께하여 포천교육의 새로운 시도를 축하했다.
이 자리에서 소성숙 교육장은 “학교와 마을이 함께 아이들의 성장을 지원하는 것은 지역의 미래를 만드는 일이다. ‘2025 포천 미래 ON 에듀페어’를 통해 포천교육의 성과를 함께 공유하고, 학생들이 미래 역량을 키워가는 계기가 되길 바라며, 앞으로도 다양한 교육활동을 의미 있게 운영하며 적극적으로 지원하겠다”고 환영사를 했다.

백영현 포천시장은 “이 행사는 학생들이 중심이 돼서 다양한 체험과 전시가 펼쳐지는 매우 의미 있는 자리이다. 학생 주도의 행사를 통해 포천의 아이들이 자신의 꿈을 찾고 미래에 역량을 키워가는 소중한 기회가 되기를 바란다. 우리 시에서도 포천교육지원청과 긴밀한 협력을 통해서 학생들의 성장을 돕고 또 교육 발전을 위한 다양한 정책들을 추진하겠다”고 축사했다.

김용태 국회의원은 “학생 여러분 토요일 아침 일찍 와 있는 것만으로도 굉장히 훌륭한 것 같다. 저는고향이 포천이지만 초등학교까지 나오고 사실 더 좋은 교육 기회를 갖고 싶어서 서울로 이사 갔었다. 더 윗세대인 40년 50년 된 선배들은 포천에서 공부하다가 조금 더 좋은 교육 기회를 받고 싶어서 타 도시로 유학을 가곤 했다. 국회의원으로서 앞으로 포천에서만큼은 더 이상 다른 도시 학생들에 비해 교육의 기회가 열악하거나 부족해서 떠나는 일이 없도록 하는 것이 제 목표이다. 그래서 포천에 있는 학생들에게 더 많은 교육의 기회와 더 좋은 인프라를 만들기 위해 최선을 다하겠다”고 밝혔다.
특히, 지난 회차와 다른 점은 학생들이 주제를 만들고 실험한 소논문 발표회가 함께 진행되었다는 것이다.
총 12개 팀이 소논문을 위한 실험을 진행하였고, 이 중 5개 팀의 소논문이 그 자리에서 발표되었고, 이 소논문이 모두 담겨 있는 책자도 발간되었다.


그 중 첫번째 발표된 소논문이 김수인·김시은·김지윤학생이 결성한 ‘삼김’팀이 신여진 교사의 지도를 받아 실험한 ‘천연식물 추출물을 이용한 세균 성장 억제 효과 비교 연구’는 상당히 재미있는 실험이었다.
학생들이 비교적 실행하기 쉽도록 계피, 생강, 녹차 추출물 및 대조군을 하나의 배지에 두고 실험한 것이 흥미로왔다. 특히 내용 중에 인큐베이터에서 실험 배지를 꺼내야 하는 시기를 놓쳐, 오염으로 인해 첫번째 실험을 실패했다는 내용이 들어 있어 흥미로왔다.
두번째 실험에서는 비교적 결과가 선명하게 나왔는데 생강, 계피, 녹차 추출액 순으로 항균 효과가 있는 것으로 나타났다. 참가 학생들은 소논문의 끝에서 실험 결과가 책을 보고 공부한 것과는 약간 다르게 나왔다고 발표하고 있다.
아쉬운 점은 비록 교사의 지도를 받아서 실행하는 연역적 실험이지만, 실험에 사용하는 배지를 하나만 사용하였다는 것이 아쉽다면 아쉬운 점이다. 어차피 인규베이터 한 층을 다 사용할 거라면 4개~5개까지 배지를 만들어서 사용했다면 과학적으로 좀 더 의미있는 소논문이 나왔을 것이라는 아쉬움이 있다.


체험 부스들 가운데서는 유독 초등학생들이 많이 줄을 서 있는 부스를 찾았다.
최근 포천의 초등·중학생들이 가장 많이 하는 게임인 ‘로블록스’를 이용해서 자체 제작한 게임을 들고 나온 팀이 있어서 인터뷰를 했다.
포천고등학교 장민성·엄지성·이태형 세 학생이 ‘로블록스’내에서 방탈출 게임과 장애물 넘기가 혼합된 게임을 만들어서 부스를 운영하였다.
준비한 게임이 어떤 내용인지 묻자, 장민성 학생은 “로블록스 내에서 초등학생에게 가장 인기가 많은 게임이 있다. 그것을 모티브로해서 점프 등을 해서 탈출을 하는 게임이다”라고 설명을 했다.
‘로블록스’라는 게임은 어떤 것인지 물으니 “로블록스는 일종의 플랫폼이다. 다른 이의 게임을 실행할 수도 있고, 내가 게임을 만들 수도 있다. 부스 운영을 위해 시험이 끝나고 3주정도 3명이서 만들었다”면서 “한 번에 탈출한 친구들에게는 초콜렛을 선물로 준다”고 했다.
‘로블록스’라는 게임은 게임계에서는 유튜브, 멜론, 카카오톡, 토스뱅크 등의 기능이 같이 있는 플랫폼이라고 할 수 있다. 어르신들이 유튜브의 세게에서 살고 있는 것처럼, 초등학생과 중학생은 ‘로블록스’의 세계에 살고 있다고 해도 과언이 아니다.
‘2025 포천 미래 ON 에듀페어’에서 아쉬운 점은 비록 행사를 크게 확장 개편하고, 이름이 변하기는 했지만, 지난 해까지 운영되었던 ‘수·정·과 체험전’과의 회차 연계성을 없애 버린 것이 몹시 아쉬웠다. 이런 회차들이 모여서 하나의 전통과 교육적 문화로 자리잡을 기회를 가지게 되는 것이다. 첨언하여 회차를 억지로 따지면, 이번 ‘2025 포천 미래 ON 에듀페어’는 ‘수·정·과 체험전’으로부터 따지면 ‘제6회’가 되는 것이다.
[ 포천좋은신문 문석완 기자 ]





















